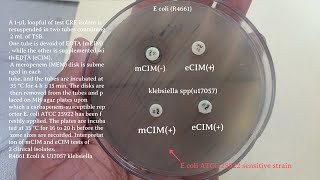

mCIM e CIM testing for CRE isolates video
Online izle ve mp4 mp3 formatlarinda yukle
Videonun muddeti: 11:00
mCIM e CIM testing for CRE isolates videosu mp4 ve mp3 yuklemek ucun hazirdir
Diqqet! Siz Mp4 yukle ve ya Mp3 yukle duymesine basdiqdan sonra eger sistem sizi reklam sehifesine atarsa o zaman derhal geri qayidib emeliyyati tekrar edin ve faylin yuklemek ucun hazir olmasini gozleyin
Videodan Mp4 Yukle
Videodan Mp3 Yukle-1
Videodan Mp3 Yukle-2
Oxshar Axtarishlar
mCIM e CIM testing for CRE isolates
modified Carbapenem Inactivation Method (mCIM)
Diffusion en direct de MCIM TEST TEST
Diffusion en direct de MCIM TEST TEST
Carbapenem-resistant Detection K-Set-Era Biology
MCiM Virtual Information Session - July 26, 2023
Stanford Master of Science in Clinical Informatics Management (MCiM)
TEST
mCIM, eCIM e sCIM
Video Mp4 Mp3Azwap.Biz
Azwap.Biz 2021-2023